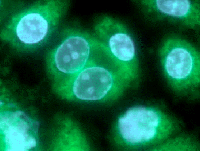

Sodium Channel
noise - alternative - sonicscapes - radiohead - pink floyd - beatles - british pop - new music - cool - weird - dark - power
11
songs
847
plays

Stare Stare

Mr M Mr M

Dead Kitty (mind your own) Dead Kitty (mind your own)
Show all (11)
WELCOME to the sonic-world of Sodium Channel.
please visit:
www.sodiumchannel.com
www.myspace.com/sodiumchannel
www.sonicbids.com/sodiumchannel
www.garageband.com/sodiumchannel
...and enjoy the ride!Band/artist history
Please check www.sodiumchannel.comHave you performed in front of an audience?Yes. Anywhere.
Your musical influences
Lots of stuff. So much that it dissappears in the overall sound of the band.What equipment do you use?
Long list. And keeps growing every day. No! We cannot stop it!!Anything else?
EP titled [Reverse Obvious] for sale on our website. Full length CD coming soon!
San Francisco, CA
USA
ID
105904
Contact
Sorry, this artist currently doesn't accept email messages.
Comments (3)
1) Get your stuff mastered
2) Get it infront of a&r people as soon as possible
Sounding good NaCH!!
heard some new stuff from you guys here.
love that song stare. good tone! good groove.
-G
Promoted
Not related to artist